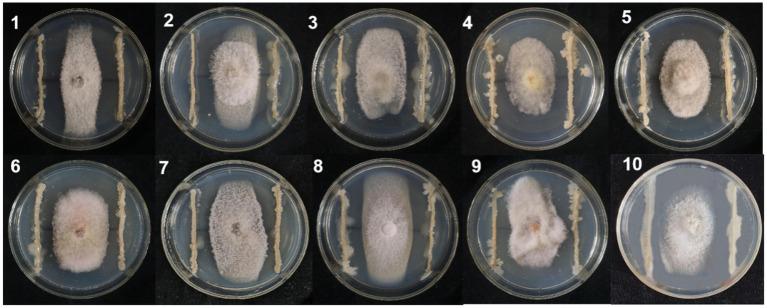
https://cdn.ncbi.nlm.nih.gov/pmc/blobs/660e/10623355/fc88b509ab70/fmicb-14-1275986-g001.jpg
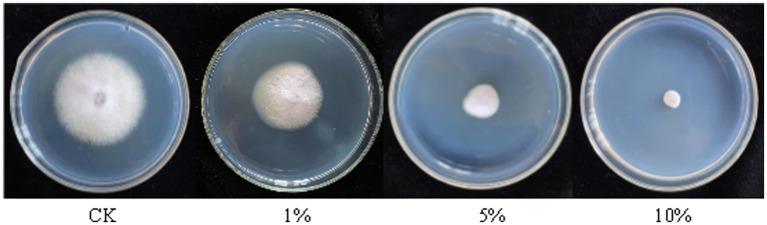
https://cdn.ncbi.nlm.nih.gov/pmc/blobs/660e/10623355/77e580a73947/fmicb-14-1275986-g005.jpg

BVE7作为一种有前景的用于生物防治由……引起的大豆根腐病的制剂。 (原文中“caused by”后缺少具体病原体信息)
BVE7 as a promising agent for biocontrol of soybean root rot caused by .
作者信息
Sun Lei, Wang Wei, Zhang Xue, Gao Zhongchao, Cai Shanshan, Wang Shuang, Li Yonggang
机构信息
Heilongjiang Academy of Black Soil Conservation & Utilization, Harbin, China.
College of Plant Protection, Northeast Agricultural University, Harbin, Heilongjiang, China.
出版信息
Front Microbiol. 2023 Oct 20;14:1275986. doi: 10.3389/fmicb.2023.1275986. eCollection 2023.
INTRODUCTION
Soybean root rot (SRR), caused by , is a severe soil-borne disease in soybean production worldwide, which adversely impacts the yield and quality of soybean. The most effective method for managing crop soil-borne diseases and decreasing reliance on chemical fungicides, such as spp., is via microbial biocontrol agents.
METHODS AND RESULTS
In this study, a soil-isolated strain BVE7 was identified as , exhibiting broad-spectrum activity against various pathogens causing soybean root rot. BVE7 sterile filtrate, at a concentration of 10%, demonstrated significant antifungal activity by inhibiting the conidial germination, production, and mycelial growth of by 61.11%, 73.44%, and 85.42%, respectively, causing hyphal malformations. The antifungal compound produced by BVE7 demonstrated adaptability to a standard environment. The pot experiment showed that BVE7 suspension could effectively control soybean root rot, with the highest control efficiency of 75.13%. Furthermore, it considerably enhanced the activity of catalase, phenylalanine ammonia lyase, superoxide dismutase, and peroxidase in soybean roots, while also preventing an increase in malondialdehyde activity. By improving the host resistance towards pathogens, the damage caused by fungi and the severity of soybean root rot have been reduced.
DISCUSSION
This study presents the innovative utilization of , isolated from soybean roots in cold conditions, for effectively controlling soybean root rot caused by . The findings highlight the remarkable regional and adaptive characteristics of this strain, making it an excellent candidate for combating soybean root rot in diverse environments. In conclusion, BVE7 demonstrated potential in effectively reducing SRR incidence and can be considered as a viable option for SRR management.
引言
由[未提及具体病原菌]引起的大豆根腐病(SRR)是全球大豆生产中一种严重的土传病害,对大豆的产量和品质产生不利影响。管理作物土传病害并减少对化学杀菌剂(如[未提及具体杀菌剂种类])依赖的最有效方法是通过微生物生物防治剂。
方法与结果
在本研究中,从土壤中分离出的菌株BVE7被鉴定为[未提及具体菌种],对引起大豆根腐病的各种病原菌具有广谱活性。浓度为10%的BVE7无菌滤液通过抑制[未提及具体病原菌]的分生孢子萌发、产生和菌丝生长,分别达到61.11%、73.44%和85.42%,显示出显著的抗真菌活性,导致菌丝畸形。BVE7产生的抗真菌化合物在标准环境中表现出适应性。盆栽试验表明,BVE7悬浮液能有效控制大豆根腐病,最高防治效率达75.13%。此外,它还显著提高了大豆根中过氧化氢酶、苯丙氨酸解氨酶、超氧化物歧化酶和过氧化物酶的活性,同时还防止了丙二醛活性的增加。通过提高宿主对病原菌的抗性,减少了真菌造成的损害和大豆根腐病的严重程度。
讨论
本研究展示了在寒冷条件下从大豆根部分离出的[未提及具体菌种]在有效控制由[未提及具体病原菌]引起的大豆根腐病方面的创新应用。研究结果突出了该菌株显著的区域和适应特性,使其成为在不同环境中对抗大豆根腐病的优秀候选菌株。总之,BVE7在有效降低SRR发病率方面显示出潜力,可被视为SRR管理的可行选择。